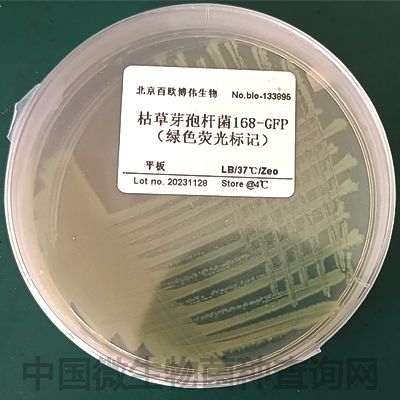
枯草芽孢杆菌168-GFP（绿色荧光标记）

万千商家帮你免费找货
0 人在求购买到急需产品
- 详细信息
- 询价记录
- 技术资料
- 库存:
1000
- 英文名:
枯草芽孢杆菌168-GFP(绿色荧光标记)
- 保质期:
3年
- 供应商:
百欧博伟
- 保存条件:
-80
平台编号:bio-133895
一、菌种简介
1、菌种名称Bacillus subtilis
2、生物危害程度:四类
二、储存条件
甘油菌种(甘油终浓度15%)请置于-80℃保藏,平板请置于4℃保藏
三、培养条件
1、培养基成分:蛋白胨10g,酵母粉5g,NaCl 10g,蒸馏水 1.0L,pH 7.0。121℃,20分钟灭菌,固体培养基另加1.5%-2%的琼脂粉
2、需氧类型:好氧
3、培养温度:37℃(基因组中含有博来霉素抗性,培养时可添加)
四、注意事项
1、菌种常规培养时间:细菌24-48h,酵母72h,霉菌5-7d,大型真菌7-10d。
2、平板请尽快转接,存放时间不得超过1个月,﹣80℃甘油菌1年更换一次
风险提示:丁香通仅作为第三方平台,为商家信息发布提供平台空间。用户咨询产品时请注意保护个人信息及财产安全,合理判断,谨慎选购商品,商家和用户对交易行为负责。对于医疗器械类产品,请先查证核实企业经营资质和医疗器械产品注册证情况。
- 作者
- 内容
- 询问日期
技术资料暂无技术资料 索取技术资料
枯草芽孢杆菌168-GFP(绿色荧光标记)
询价